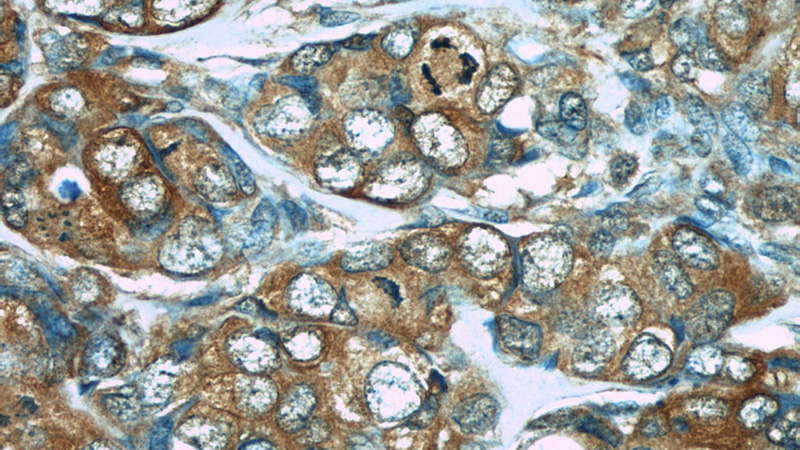
Immunohistochemistry of paraffin-embedded human breast cancer slide using Catalog No:107460(PDCD4 Antibody) at dilution of 1:50

-
Product Name
PDCD4 antibody
- Documents
-
Description
PDCD4 Mouse Monoclonal antibody. Positive IHC detected in human breast cancer tissue, human gliomas tissue. Positive WB detected in HeLa cells, HEK-293 cells, Jurkat cells. Observed molecular weight by Western-blot: 56 kDa
-
Tested applications
ELISA, IHC, WB
-
Species reactivity
Human; other species not tested.
-
Alternative names
H731 antibody; Nuclear antigen H731 like antibody; PDCD4 antibody; Protein 197/15a antibody
-
Isotype
Mouse IgG1
-
Preparation
This antibody was obtained by immunization of PDCD4 recombinant protein (Accession Number: NM_014456). Purification method: Protein G purified.
-
Clonality
Monoclonal
-
Formulation
PBS with 0.02% sodium azide and 50% glycerol pH 7.3.
-
Storage instructions
Store at -20℃. DO NOT ALIQUOT
-
Applications
Recommended Dilution:
WB: 1:1000-1:10000
IHC: 1:20-1:200
-
Validations
Immunohistochemistry of paraffin-embedded human breast cancer slide using Catalog No:107460(PDCD4 Antibody) at dilution of 1:50

HeLa cells were subjected to SDS PAGE followed by western blot with Catalog No:107460(PDCD4 Antibody) at dilution of 1:4000
-
Background
Programmed cell death 4 (Pdcd4) is a novel tumor suppressor that inhibits translation, progression and invasion. It was first identified as being differnetially upregulated during apoptosis. Pdcd4 interferes with the activity of the eukaryotic initiation factor (eIF) 4A by displacing the scaffold protein eIF4G from its binding to the RNA helicase eIF4A.
Related Products / Services
Please note: All products are "FOR RESEARCH USE ONLY AND ARE NOT INTENDED FOR DIAGNOSTIC OR THERAPEUTIC USE"
